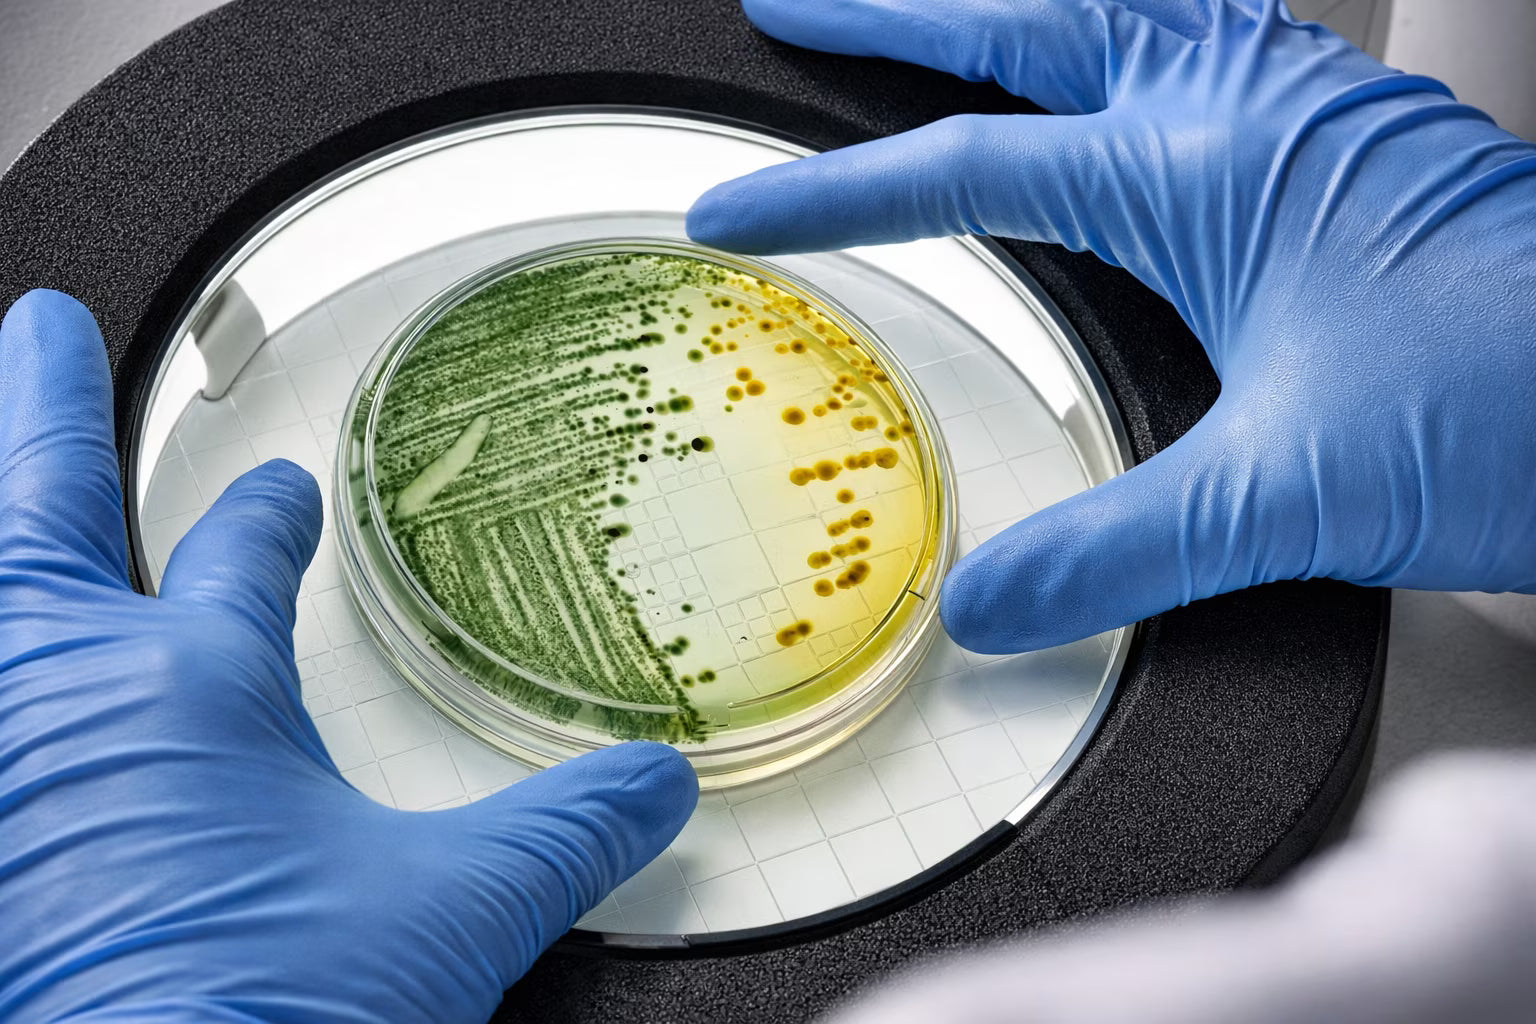

Une Science au Service de Votre Bien-Être
Notre mission est de démocratiser l'excellence scientifique en matière de santé du microbiome.
Nous sommes guidés par un objectif unique : permettre une meilleure santé grâce à une science probiotique qui apporte des résultats concrets.
Nos produits reposent sur les plus hauts standards de concentration, de qualité et de traçabilité.
Prendre soin de son Microbiote, c’est prendre soin de soi.
LA DIFFÉRENCE VITAL RITUAL : RIGUEUR SCIENTIFIQUE & TRANSPARENCE TOTALE
Notre approche demeure inchangée : créer des produits ancrés dans les données scientifiques, soumis à un double contrôle qualité (matières premières et produit fini) pour garantir pureté et intégrité microbiologique à chaque lot. Guidés non par les tendances du marché, mais par l'exigence de traçabilité et la constance que mérite votre santé.
Nos produits sont tous fabriqués dans une usine moderne, selon les normes GMP, ISO 22000 et HACCP.
Régulièrement auditée par des organismes indépendants et répondent aux normes les plus strictes de l'industrie européenne.
Traçabilité totale
Chaque lot de Synbiotic 150™ est identifié par un numéro unique permettant de remonter jusqu'aux fournisseurs de matières premières. Une exigence de traçabilité héritée des standards pharmaceutiques.
Laboratoires indépendants
Au-delà des contrôles internes de nos fabricants, nous faisons systématiquement analyser nos lots par des laboratoires indépendants en France. Pureté microbiologique, concentration en UFC, absence de métaux lourds, absence de contaminants : rien n'est laissé au hasard.






